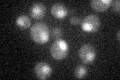
YOL054W
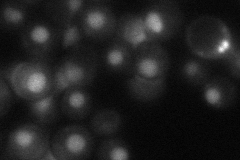
YOL054W
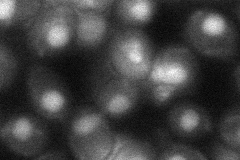
YOL054W
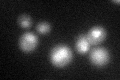
YOL054W

View description
Nuclear protein, putative RNA polymerase II elongation factor; isolated as Pob3p/Spt16p-binding protein
Localization:
Intensity:
Fold change:
Significance:
-
C’ GFP library in SD
nucleus26.18 -
N' NOP1pr-GFP in SD

nucleus91.3377 -
N' TEF2pr-mCherry in SD

nucleus135.157 -
N' NATIVEpr-GFP in SD
nucleus34.7592 -
N' TEF2pr-VC and Cyto-VN in SD
nucleus42.8339 -
C’ GFP library in SD+DTT
nucleus22.170.84No -
C’ GFP library in SD+H2O2

nucleus25.970.99No -
C’ GFP library in Starvation Media

nucleus20.450.78No -
C’ GFP library on the background of Pup2-DaMP

nucleus -
C’ GFP library on the background of CCT mutant

nucleus27.06961.03379No
